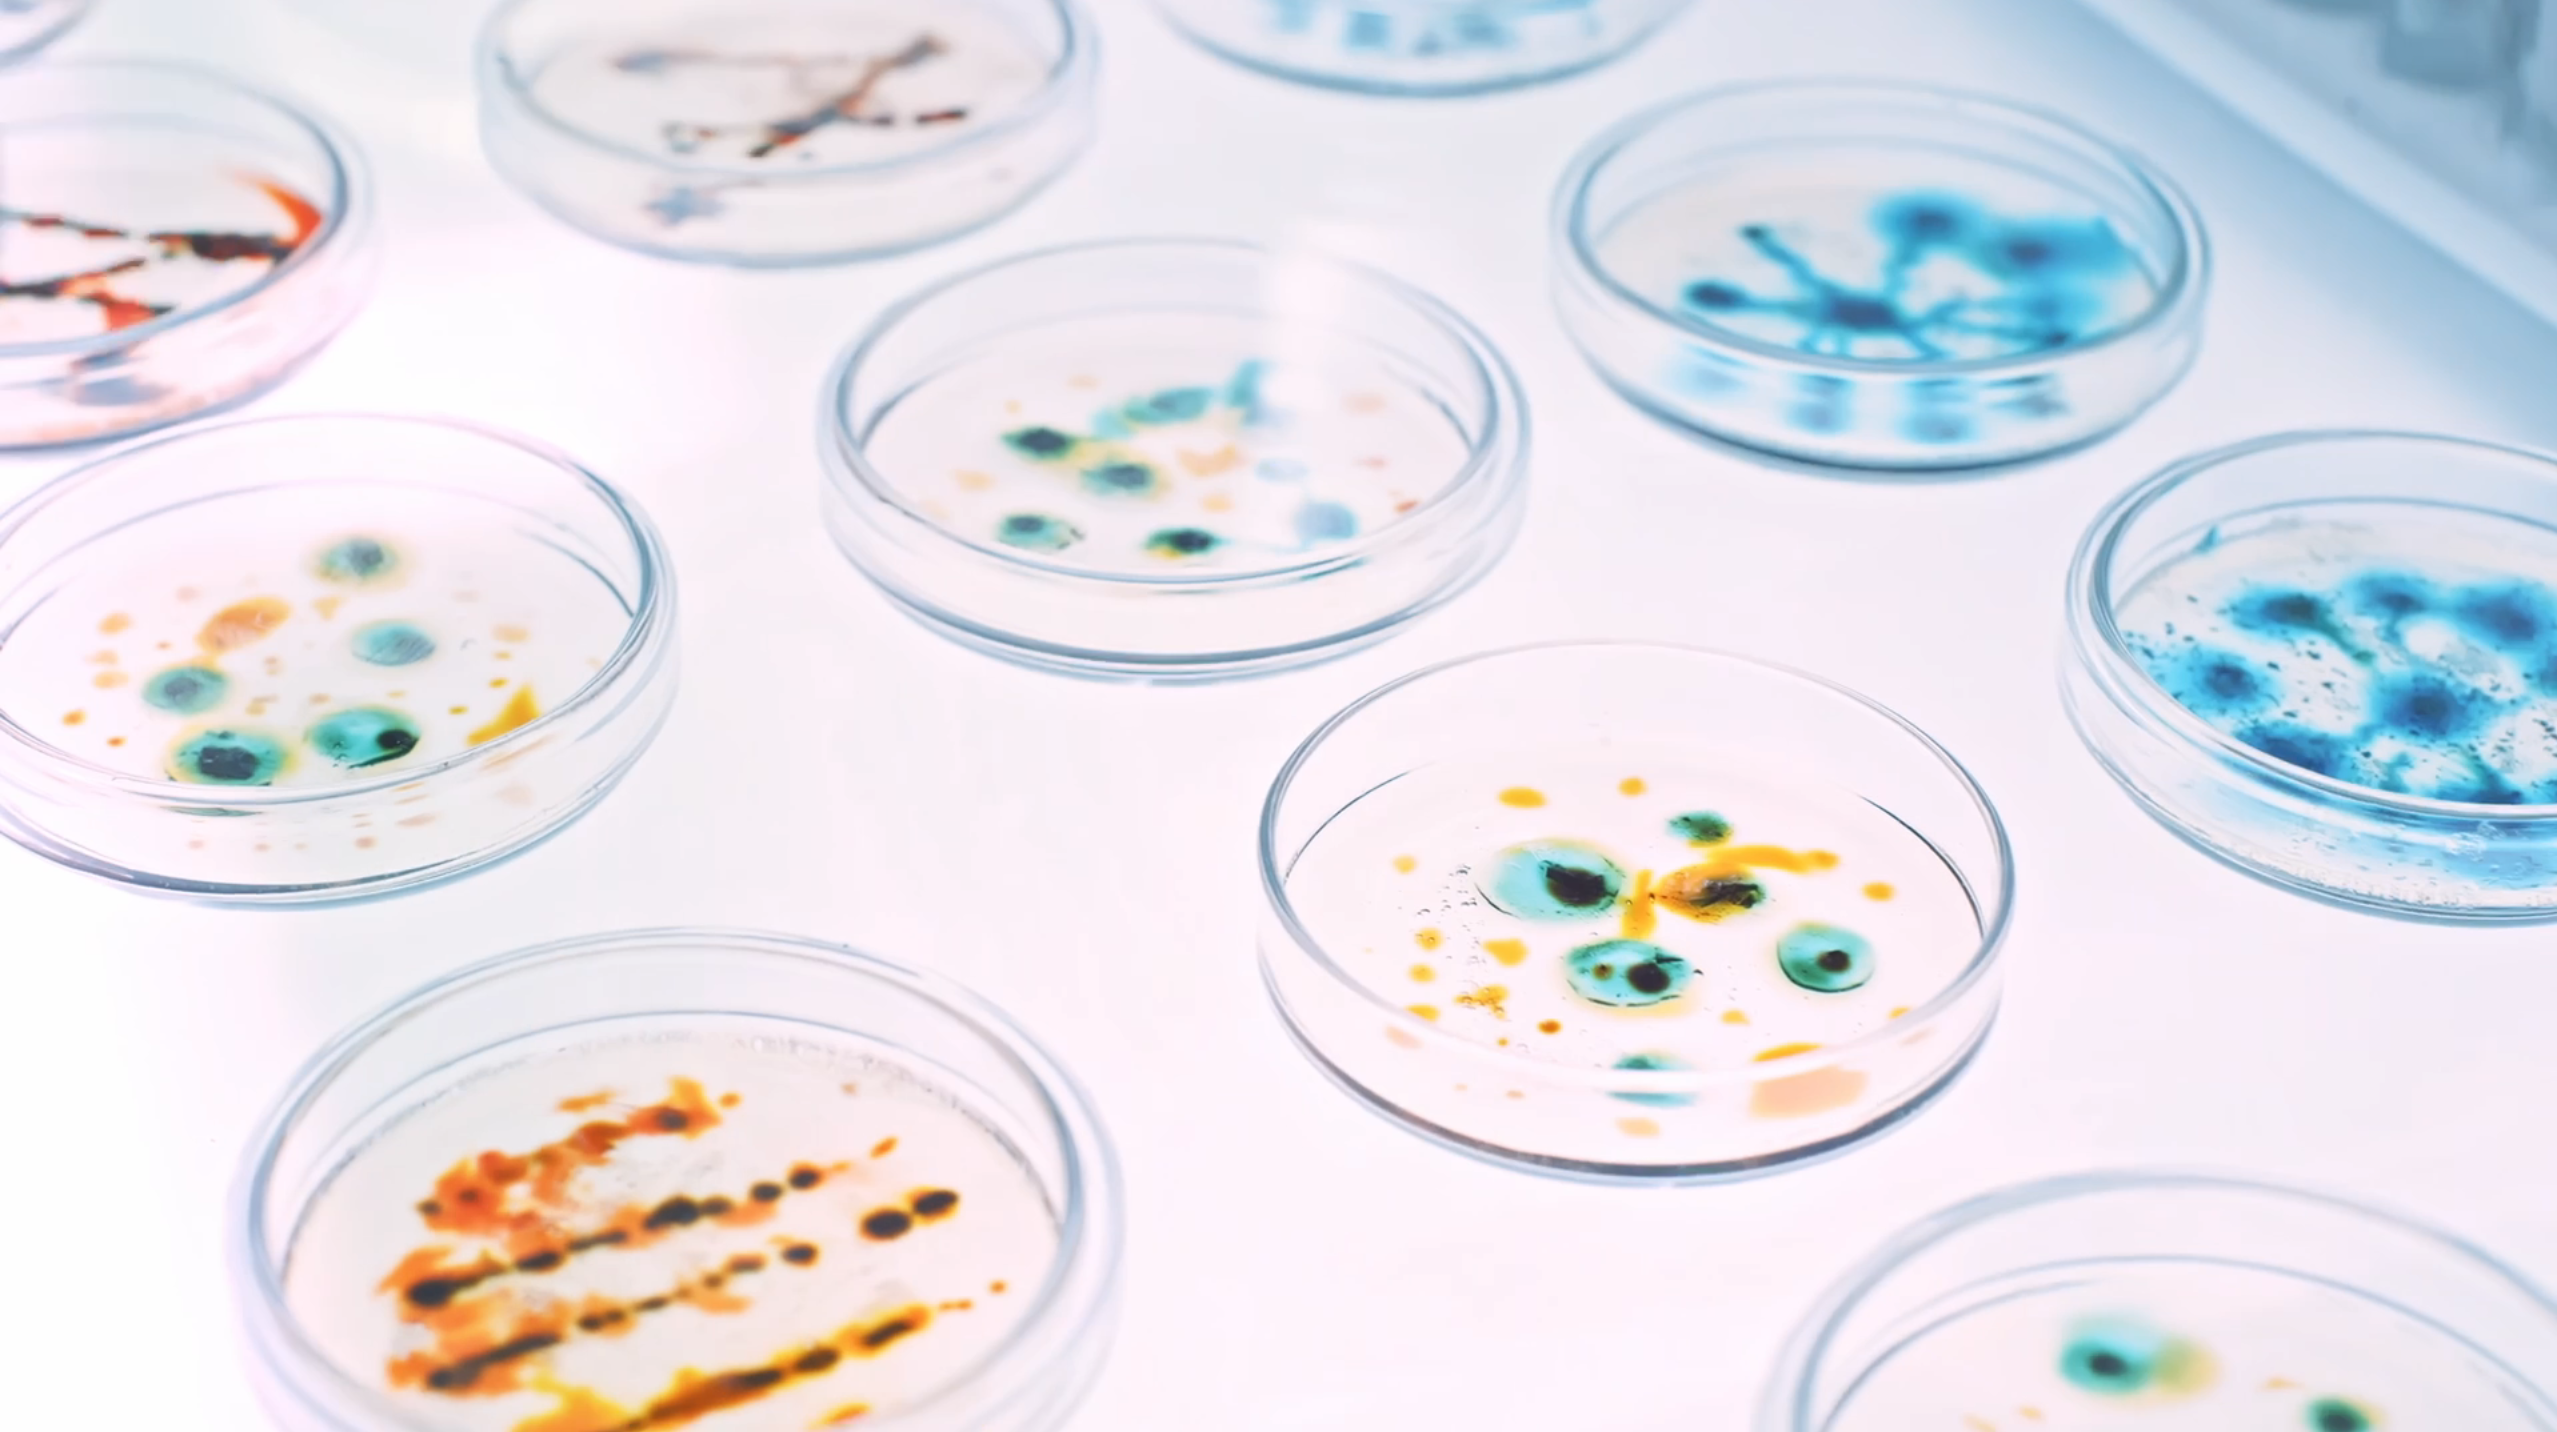
湖北绿雪生物产业有限公司

创新引领,绿色先行

科技创新出新品,价值创造赢市场,成果利益共分享
以人为本,凝聚团队力量;以精立业,满足客户需求;
以质取胜,打造一流品牌:以诚相待,提供优质服务。

致力于发展健康养殖、环保养殖、高效养殖,成为全球领先的现代化微生态高新技术企业

Copyright © 2015-2026 Cld , All Rights Reserved 湖北绿雪生物产业有限公司 版权所有 鄂ICP备2025099413号